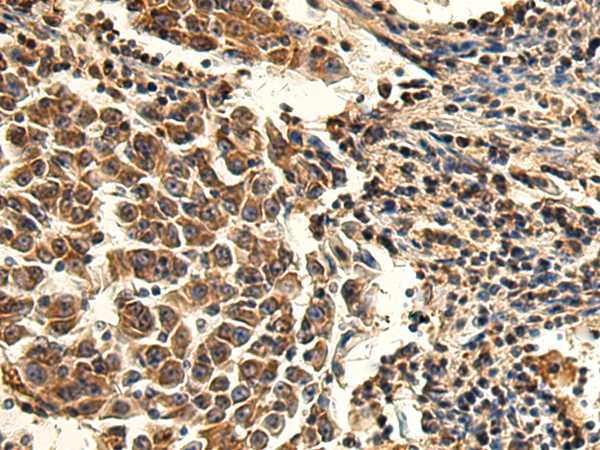
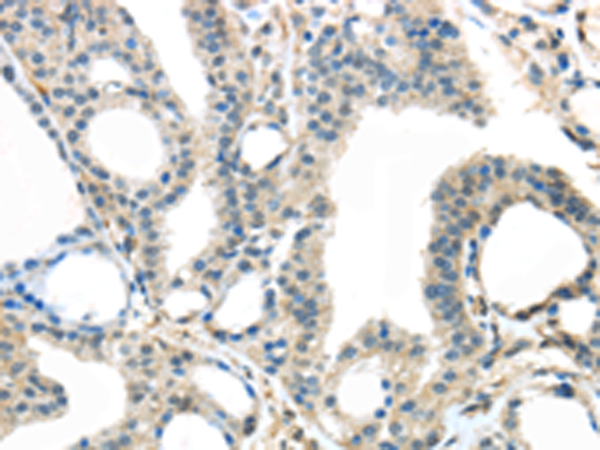
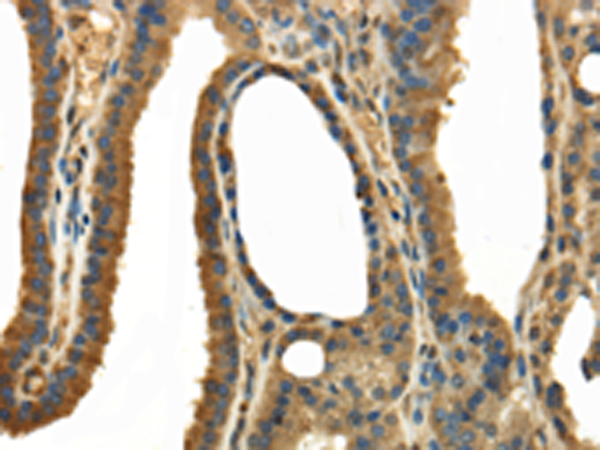

-
分类: 科研抗体货号: P08916别名: TSSC1; EIPR-1应用: IHC反应种属: Human, Mouse, Rat
-
分类: 科研抗体货号: P08899别名: TGP; hTGP应用: WB,IHC反应种属: Human
-
分类: 科研抗体货号: P08881别名: HNLF; ERS25; p24a3; GMP25iso;应用: WB,IHC反应种属: Human, Mouse
-
分类: 科研抗体货号: P08898别名: TAL; TALH; TAL-H; TALDOR应用: WB,IHC反应种属: Human, Mouse, Rat
-
分类: 科研抗体货号: P08915别名: KNP3; EREG1; TRPC7; LTRPC2; NUDT9H; NUDT9L1应用: IHC反应种属: Human
-
分类: 科研抗体货号: P08880别名: p26; P24B; C15orf22应用: IHC反应种属: Human, Mouse, Rat
-
分类: 科研抗体货号: P08914别名: TRUSS; TRRP4AP; PPP1R158; C20orf188应用: IHC反应种属: Human, Mouse
-
分类: 科研抗体货号: P08897别名: MILT1; OIP106应用: IHC反应种属: Human
-
分类: 科研抗体货号: P08879别名: p24; P24A; RNP24应用: WB,IHC反应种属: Human, Mouse, Rat
-
分类: 科研抗体货号: P08913别名: INrf2; KLHL19应用: IHC反应种属: Human, Mouse, Rat

鄂公网安备42018502007531号
鄂公网安备42018502007531号

